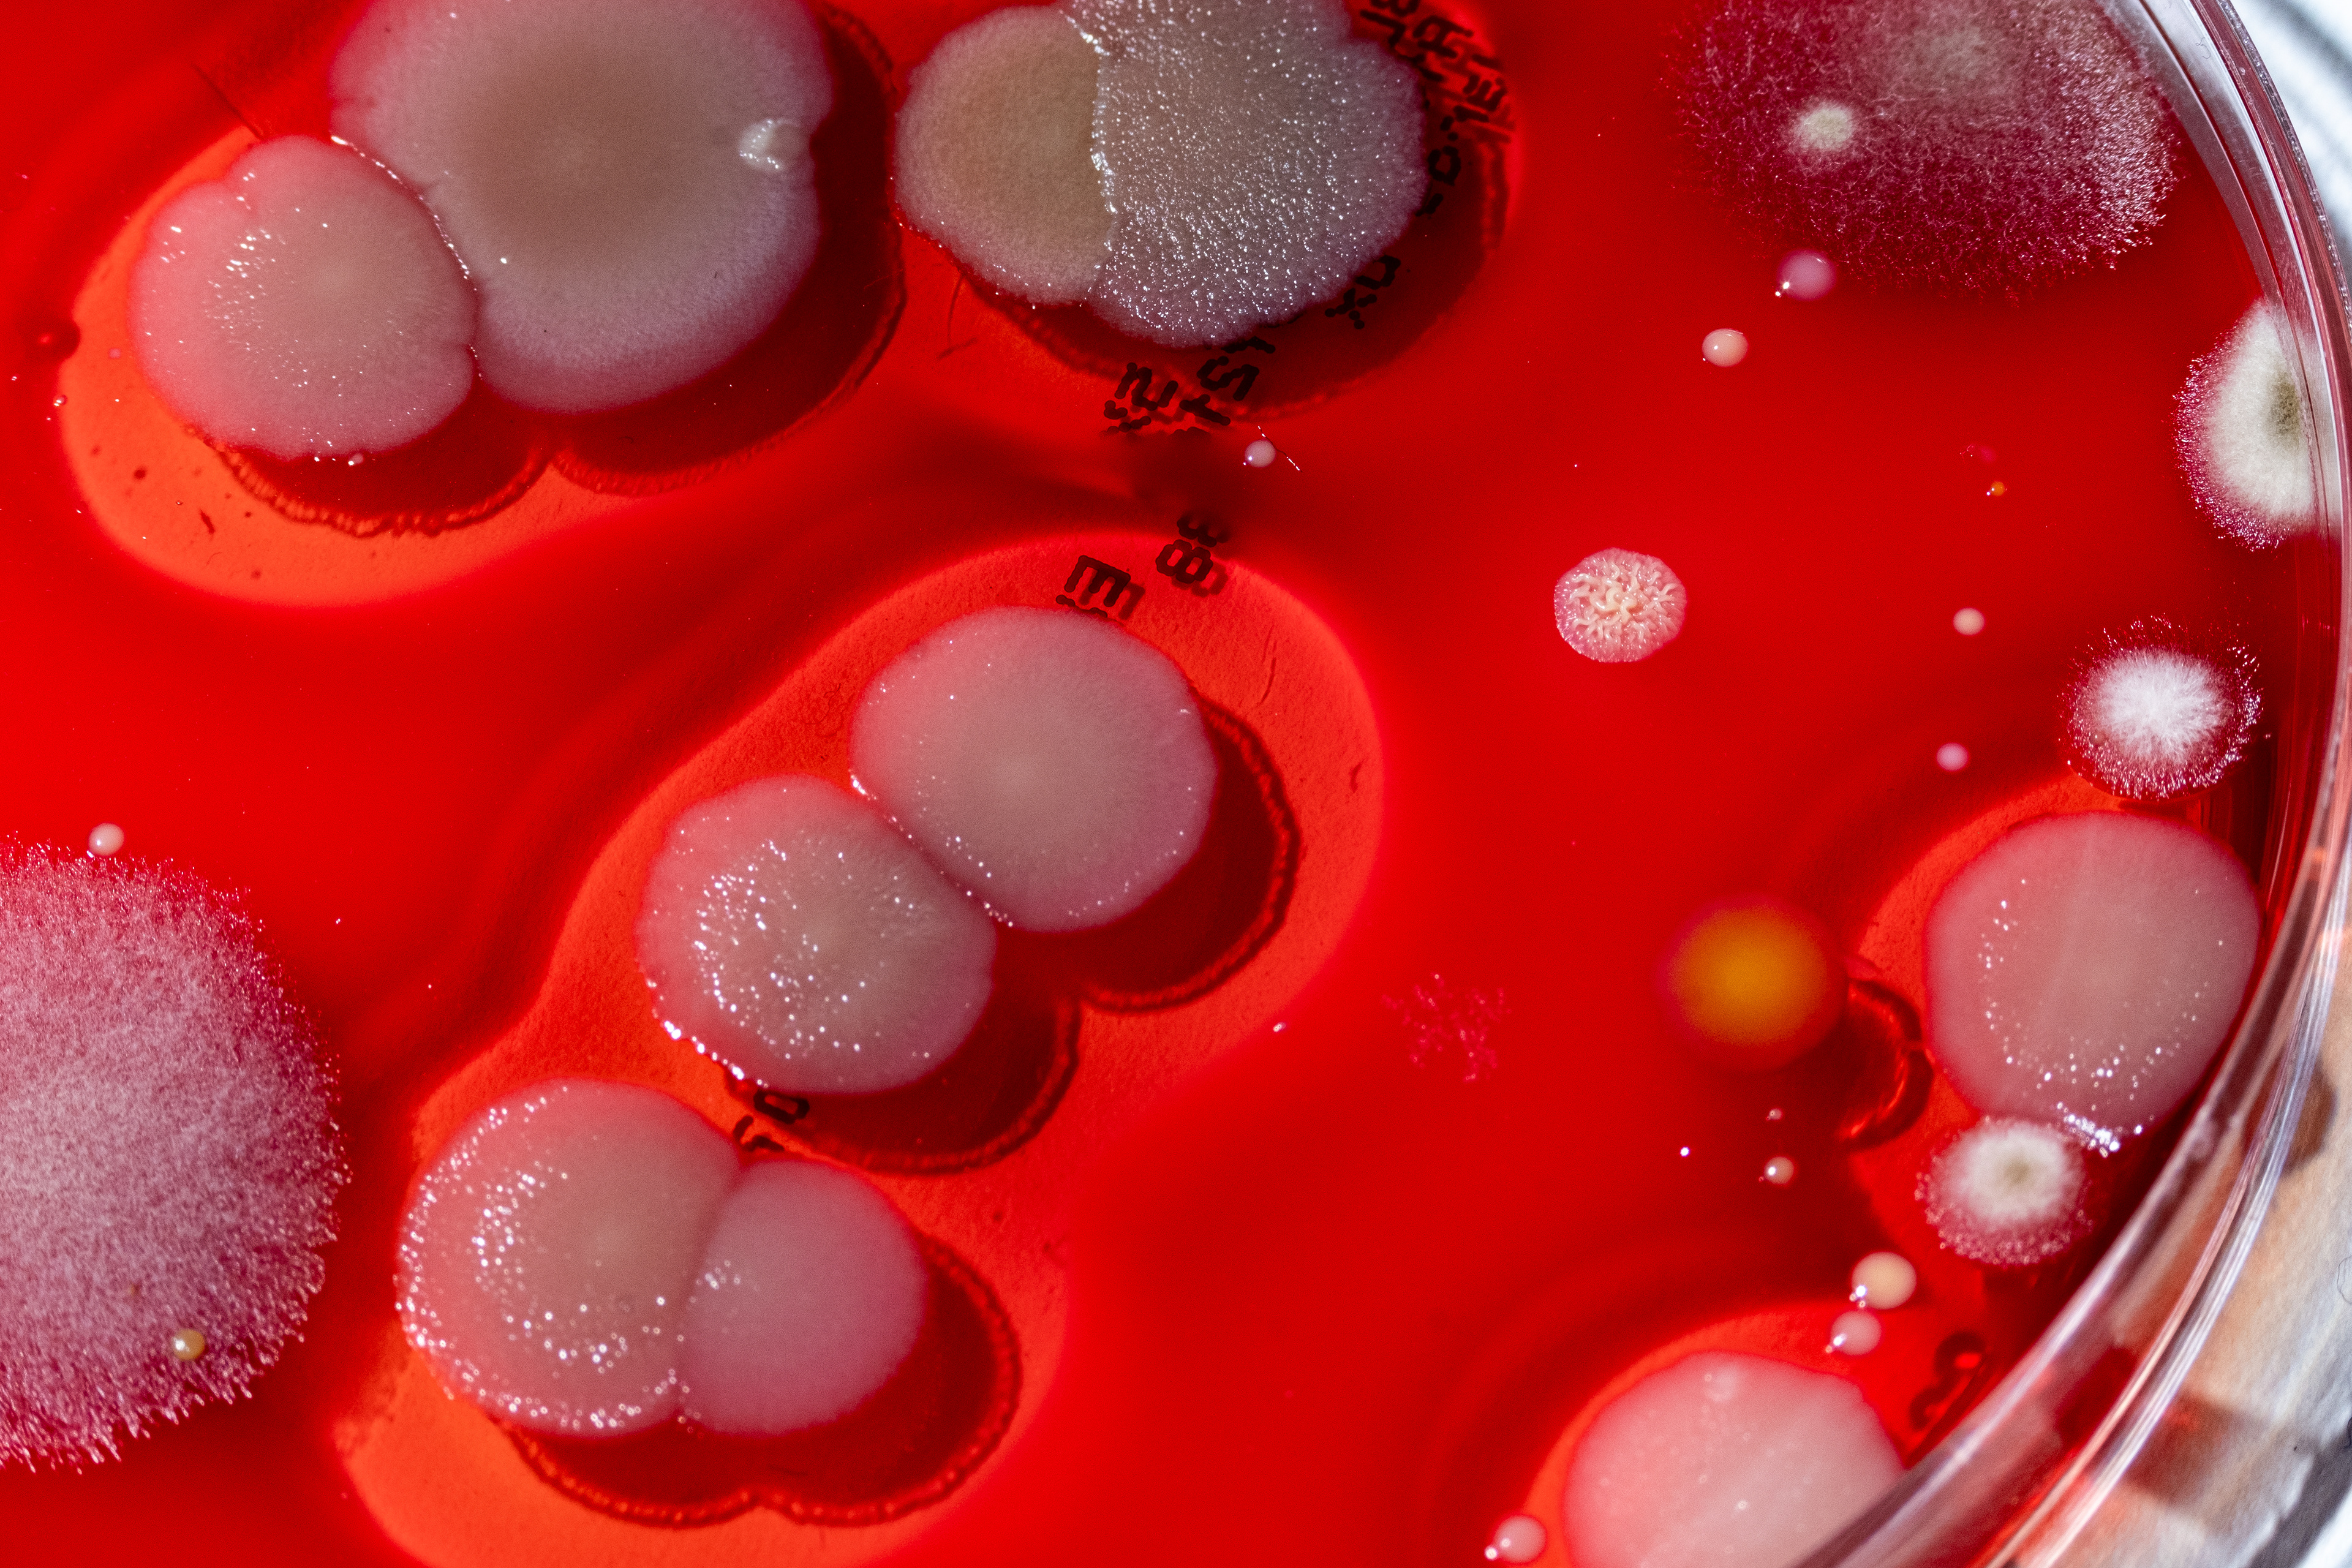

From Britannica:
“eclogue, a short pastoral poem, usually in dialogue, on the subject of rural life and the society of shepherds, depicting rural life as free from the complexity and corruption of more civilized life.”
Eclogue is an exploration of identity, time, and existence through cultured Petri dishes in comparison to nature. Just as we live on the earth and interact with the exterior, the microorganisms on our bodies do the same. We are both aliens in a foreign place, exploring until we die. Microbes, though minute and invisible to the naked eye, are a microcosm of the natural world’s processes.
Programs: Adobe Lightroom, Photoshop, InDesign, and OBS Studio.

Eclogue Poster

People have the instinctual need to draw comparisons, and theories for why point to it being an innately human phenomena. The similarity of a tree trunk and mold on a Petri dish is born from the universality of natural design. By recognizing patterns in nature, we project our own fears and hopes onto them. Patterns reassure a sense of continuity, that there is order beyond our comprehension. Through such patterns, we ascribe meaning; Is there a God? Is this coincidence? What systems can we mimic to improve our lives? And mitigate our fear of the inevitable: Where do we go after death?

"The process involved having ten friends, one cat, and myself touch Petri dishes with our hands. Each person interacted with the dish in their own way — some tapped it gently as if it might bite, others traced smiley faces or hearts across the agar. Over the course of seven days, the dishes were cultured, with a photo taken each day to immortalize the process. On the seventh day, the Petri dishes were examined under my microscope, with some of the cultures being swabbed and prepared as bacterial smears for observation. The nature photos are a mixture of shots taken on hikes, and staged photographs of natural ephemera I collected recently and since childhood."









Each chapter draws a comparison between the bacterial cultures and elements of the natural world (moss, lichen, mushroom, etc.) with flexibility regarding technical classifications.
A truncated version of the relevant scientific definition is included at the beginning of each chapter to provide conceptual grounding, while simultaneously functioning as a short, poetic prelude.

Lichen Intro

Moss Intro

Stone Intro

Bark Intro

Leaf Intro

Bone Intro


















